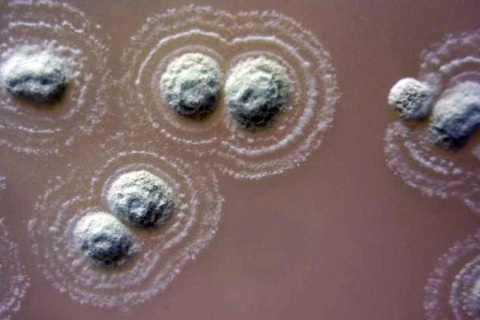
Phát hiện loại vi khuẩn đặc biệt… quanh khu định cư của người Ireland cổ đại

Thứ 4, 09/01/2019
Xu hướng
- # Quy tập hài cốt liệt sỹ tại TPHCM
- # Sắp xếp thôn, tổ dân phố
- # Những câu hỏi điểm liệt trong bài thi lý thuyết sát hạch lái xe
- # Kỳ thi tốt nghiệp THPT 2026
- # U19 Đông Nam Á 2026
- # Chiến dịch 500 ngày "trả tên" cho liệt sỹ
- # Một năm sáp nhập, vận hành chính quyền 2 cấp tại tỉnh, thành
- # Thi lớp 10 năm 2026
- # Mỹ, Israel không kích Iran